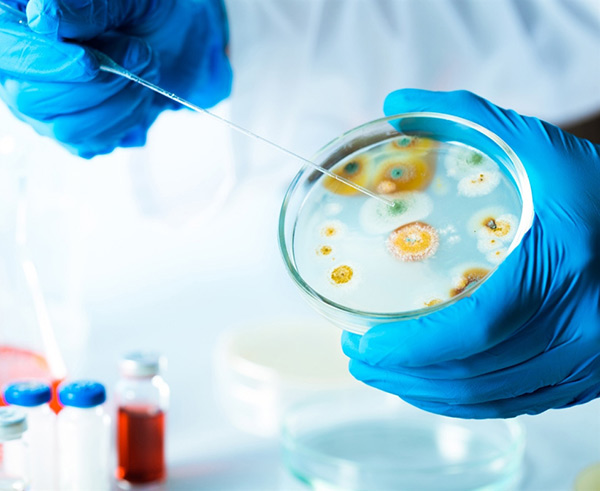

MOLD CONTAMINATION AND TYPES OF SAMPLING
Health Canada considers mold growth in residential and public buildings to be a potential health hazard, as people living or working in buildings with chronic dampness and mold are more likely to suffer from symptoms such as eyes, nose and throat irritation, coughing, wheezing, shortness of breath or other allergy like reactions.
According to Health Canada, some people are quite sensitive to mold, while others will not react at all. Therefore, Health Canada recommends that any mold that is found indoors be properly removed, regardless of the mold species found to be growing in the building.
Health Canada also notes that there is no amount of mold that can be considered safe when found in indoor environments. As such, Health Canada States that: "In the absence of exposure limits, results from tests for the presence of fungi in air cannot be used to assess risks to the health of building occupants". This means that in the presence of persons with allergic sensitizations or those with a higher susceptibility, such as newborns, people suffering from respiratory or immune system issues, or the elderly, fungi spores that are found in the indoor air, when different from outdoor levels, have to be considered a potential health hazard that may require proper cleaning.